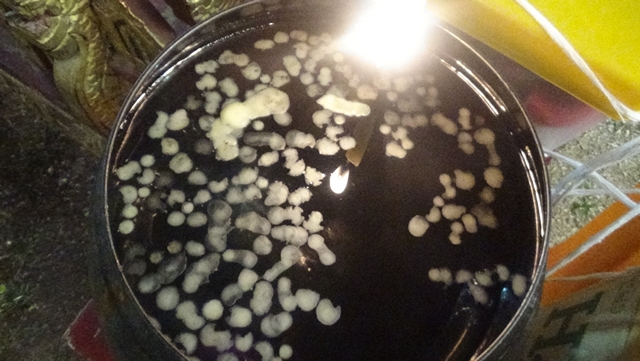

อ่างทอง-สืบสานประเพณีรับขวัญข้าวสุดยิ่งใหญ่ จัดพิธีบวงสรวงพระแม่โพสพ

อ่างทอง-สืบสานประเพณีรับขวัญข้าวสุดยิ่งใหญ่ จัดพิธีบวงสรวงพระแม่โพสพ

เมื่อวันที่ 15 เมษายน 2569 เวลา 18.39 น. ณ วัดจุฬามุนี ตำบลองค์รักษ์ อำเภอโพธิ์ทอง จังหวัดอ่างทอง ได้มีการจัดงาน “พิธีบวงสรวงบูชาแม่โพสพ (รับขวัญข้าว)” ประจำปี 2569 อย่างสมเกียรติ โดยได้รับเกียรติจาก นายกรวีร์ ปริศนานันทกุล สมาชิกสภาผู้แทนราษฎรจังหวัดอ่างทอง เป็นประธานในพิธี ซึ่งงานในครั้งนี้เป็นความร่วมมือระหว่าง บริษัท ประชารัฐรักสามัคคีจังหวัดอ่างทอง (วิสาหกิจเพื่อสังคม) จำกัด และวัดจุฬามุนี เพื่อร่วมกันเชิดชูขนบธรรมเนียมการบูชาพระแม่โพสพ เทพธิดาแห่งข้าวที่หล่อเลี้ยงชีวิตเกษตรกรมาอย่างยาวนาน

ภายในงานเต็มไปด้วยบรรยากาศแห่งความศรัทธาและความเข้มขลัง โดยมีกิจกรรมที่ได้รับความสนใจจากประชาชนและนักท่องเที่ยวเป็นจำนวนมาก อาทิการประกวดปราสาทรวงข้าว ผลงานการประดิษฐ์อันประณีตจากหยาดเหงื่อแรงกายของชาวบ้านเพื่อถวายเป็นพุทธบูชา เกษตรกรได้นำเมล็ดพันธุ์ข้าวและพืชพรรณต่างๆ เข้าร่วมพิธีเพื่อเสริมสิริมงคล เป็น “เงินขวัญถุง” นำกลับไปเพาะปลูกให้งอกเงยตามความเชื่อโบราณ
การจัดงานในปีนี้มีเป้าหมายสำคัญในการอนุรักษ์พระพุทธศาสนาควบคู่ไปกับการรักษาอัตลักษณ์ประเพณีสงกรานต์ไทย โดยทุกภาคส่วนมุ่งหวังที่จะผลักดัน งานบวงสรวงแม่โพสพ วัดจุฬามุนี ให้กลายเป็น Soft Power ที่แข็งแกร่งตามนโยบายส่งเสริมวัฒนธรรมของรัฐบาล “เป้าหมายสูงสุดคือการยกระดับงานนี้ให้เป็นเทศกาลระดับโลก เพื่อดึงดูดนักท่องเที่ยวจากทั่วทุกมุมโลกให้เดินทางมาสัมผัสรากเหง้าของวิถีเกษตรกรไทย ซึ่งจะส่งผลโดยตรงต่อการสร้างรายได้และรากฐานเศรษฐกิจที่ยั่งยืนให้กับชุมชนชาวอ่างทองอย่างภาคภูมิใจ
สำหรับงานในปีนี้ ถือเป็นภาพความงดงามแห่งศรัทธาที่หาชมได้ยาก และเป็นก้าวสำคัญในการปักหมุดให้จังหวัดอ่างทองเป็นจุดหมายปลายทางทางวัฒนธรรมที่สำคัญของประเทศไทยในปีต่อๆ ไป
สุรชัย ผลจันทร์/อ่างทอง/089-6066364
